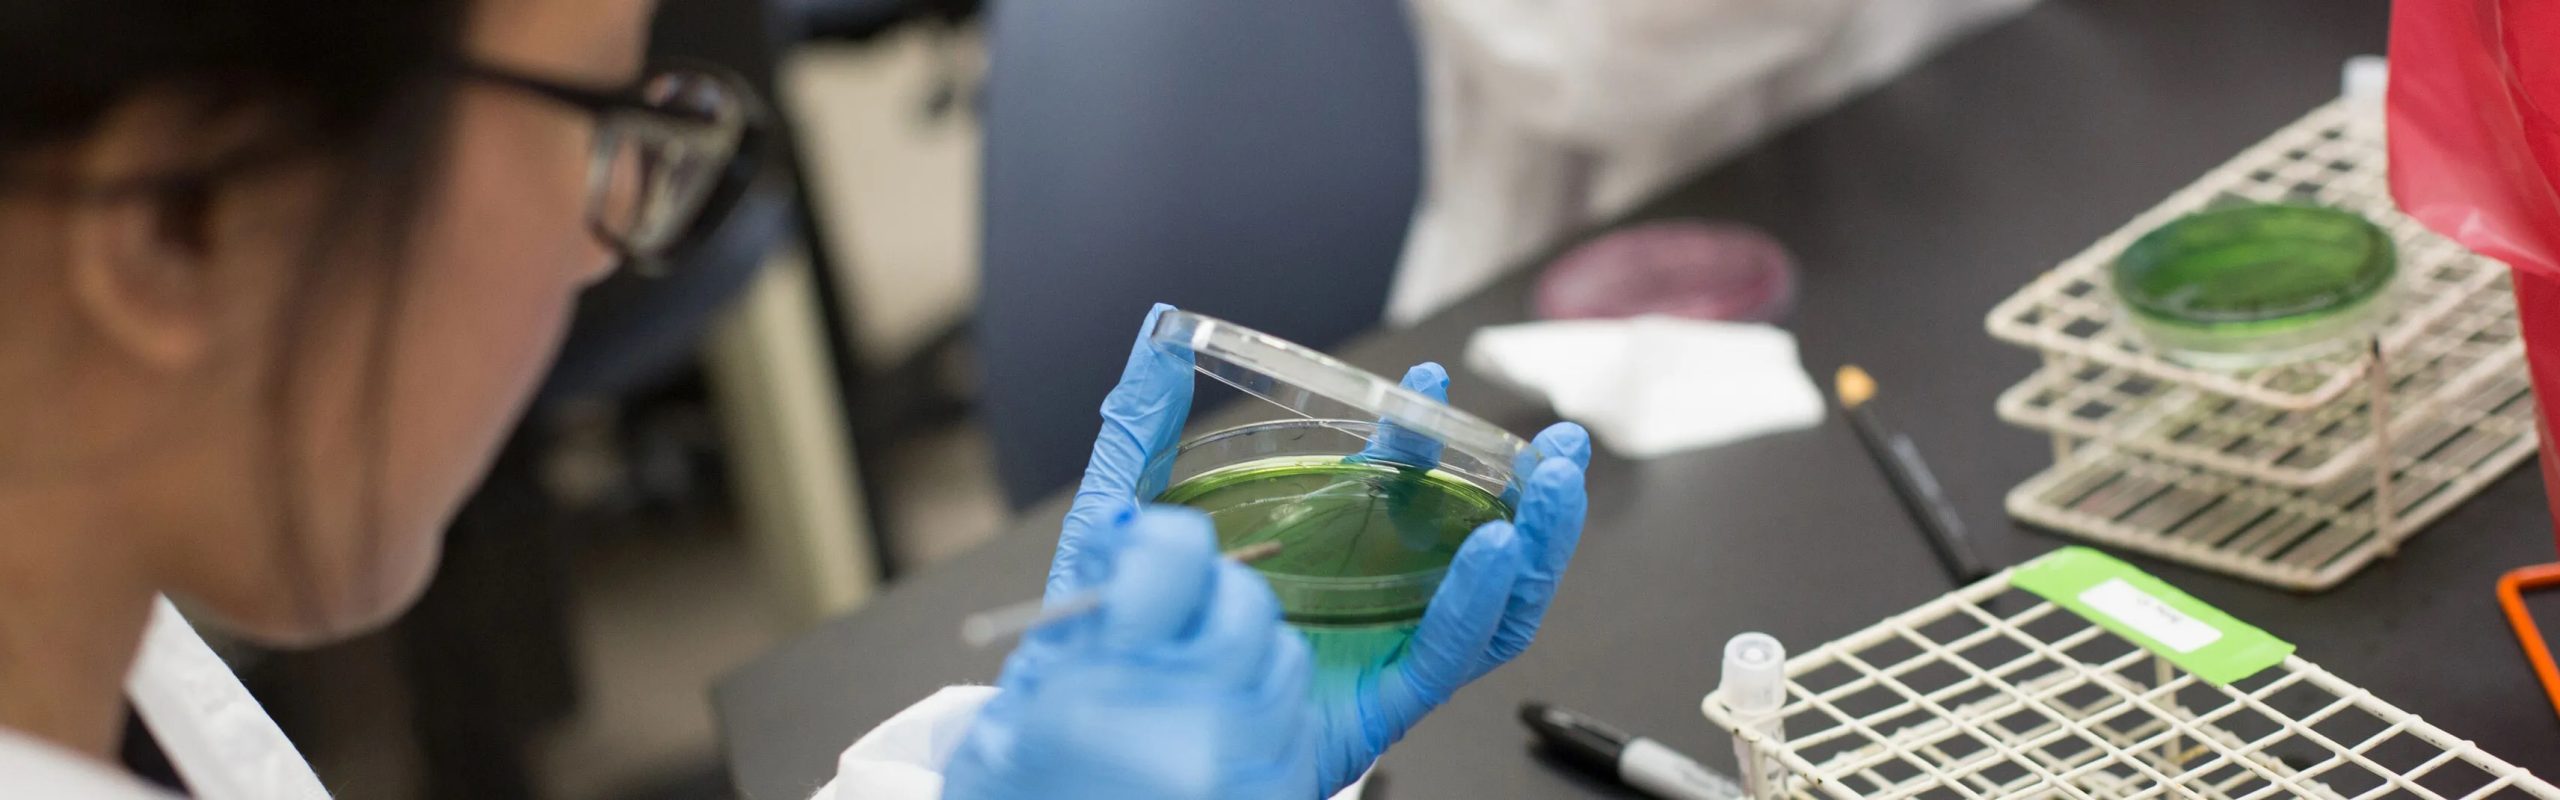

Products We Supply
Atlasbil supports the medical and laboratory sector by supplying a diverse portfolio of high-quality products from internationally recognized brands. Our range includes in vitro diagnostic (IVD) reagents, laboratory consumables, and advanced medical laboratory devices, all carefully selected to meet the highest standards of quality, reliability, and laboratory performance.
Laboratory Kits
- Immunoassay
- Biochemistry
- Microbiology
- Hematology
- Coagulation
- Genetics
- CBC


Cardiology / Surgery
- Catheters
- Stents
- PTCA Balloons
- Guide Wires
Contact Us
For more information about our products and services, or to explore potential collaborations and future projects, please feel free to contact our team. We would be pleased to assist you.